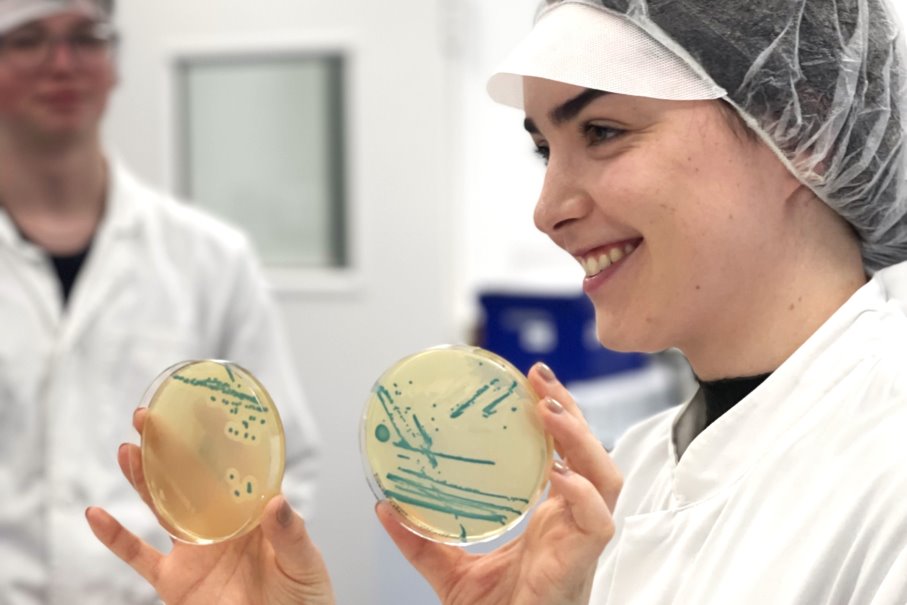

Unser Labor beim BAV Institut - Präzision, die zählt!
Für messbare Erfolge –
und ein inspirierendes Umfeld.
Unsere Arbeit steht für mehr: höchste Präzision, starken Teamgeist und echte Zukunftsperspektiven.
Sei dabei und gestalte mit uns die Zukunft!



Willkommen bei BAV
Entdecke jeden Tag Neues – mit einem Team, das dich unterstützt.
Bei BAV wirst du Teil einer Gemeinschaft, die sich mit Leidenschaft dafür einsetzt, die Qualitätsstandards in der Lebensmittel-, Kosmetik- und Arzneimittelbranche kontinuierlich zu sichern und zu optimieren.
Mit modernster Technologie, innovativen Lösungen und starkem Teamgeist schaffen wir echte Mehrwerte. Hier kannst du dich entfalten, Neues lernen und dich auf ein Team verlassen, das dich jederzeit unterstützt.
Ob spannende Projekte, vielseitige Aufgaben oder ein offenes Arbeitsumfeld – bei uns findest du die ideale Balance zwischen beruflicher Herausforderung und persönlicher Weiterentwicklung.
Willkommen bei BAV
Bringe dein Können und Wissen ein – mit starkem Teamgeist einen Mehrwert schaffen!
Bei BAV wirst du Teil einer Gemeinschaft, die sich mit Leidenschaft dafür einsetzt, die Qualitätsstandards in der Lebensmittel-, Kosmetik- und Arzneimittelbranche kontinuierlich zu sichern und zu optimieren.
Mit modernster Technologie, innovativen Lösungen und starkem Teamgeist schaffen wir echte Mehrwerte. Hier kannst du dich entfalten, Neues lernen und dich auf ein Team verlassen, das dich jederzeit unterstützt.
Ob spannende Projekte, vielseitige Aufgaben oder ein offenes Arbeitsumfeld – bei uns findest du die ideale Balance zwischen beruflicher Herausforderung und persönlicher Weiterentwicklung.



Perspektiven bei BAV
Aktuelle Stellenangebote
Aushilfen und Ferienjobber (m/w/d)
(m/w/d) | Geringfügig beschäftigt, Werkstudent
Details zur Stelle
- Unterstützung unserer Laboranten im Labor bei z. B. der Herstellung von Nährmedien, den mikrobiologischen Untersuchungen von Lebensmitteln, Kosmetika, Wasser und Arzneimitteln
- Verpacken und Versandfertigmachen der hergestellten Medien
- Sonstige Laborarbeiten
- Ausbildung z.B. als BTA, VMTA, CTA oder Studium der Biologie, Biotechnologie, Angewandte Biologie, Verfahrenstechnik oder ähnliche Fachrichtungen
- Bewusstsein für hygienisches und sorgfältiges Arbeiten
- Einsatzbereitschaft, Belastbarkeit und Flexibilität
Laborant für Eignungsprüfungen (m/w/d)
(m/w/d) | Vollzeit, Teilzeit
Details zur Stelle
- Unterstützung bei der Neu- und Weiterentwicklung von Methoden und Optimierung bestehender Prozesse
- Anmeldung, Organisation, Durchführung von Sonderuntersuchungen, Eignungsprüfungen und Validierungen
- Auswertung und Dokumentation
- Probeneinwaage, -vorbereitung und -management
- Auswertung und Diagnostik der Proben
- Maßnahmen der Qualitätskontrolle
- Eine abgeschlossene Ausbildung z. B. als BTA, CTA, MTA, Biologielaborant
- Präzise und schnelle Arbeitsweise
- Einsatzbereitschaft, Lernbereitschaft, Belastbarkeit und Flexibilität
- Gute Deutsch- und/oder Englischkenntnisse
Laborant für die Probenvorbereitung (m/w/d)
(m/w/d) | Vollzeit, Teilzeit
Details zur Stelle
- Beschriften von Proben
- Einwiegen von Lebensmitteln und Kosmetika
- Pipettieren
- Diverse weitere Laborarbeiten
- Eine abgeschlossene Ausbildung z. B. als BTA, CTA, MTA oder Quereinsteiger mit Hygieneverständnis und ausgeprägter Feinmotorik
- Präzise und schnelle Arbeitsweise
- Einsatzbereitschaft, Lernbereitschaft, Belastbarkeit und Flexibilität
- Bereitschaft zur Spätschicht und Wochenenddiensten
- Gute Deutsch- und/oder Englischkenntnisse
Laborant für unser Mikrobiologielabor (m/w/d)
(m/w/d) | Vollzeit, Teilzeit
Details zur Stelle
- Probeneinwaage, -vorbereitung und -management
- Auswertung und Diagnostik der Proben
- Identifizierungen mittels MALDI-TOF
- Durchführung von Untersuchungen mittels Real-Time PCR
- Unterstützen bei Neu- und Weiterentwicklung von Methoden
- Maßnahmen der Qualitätskontrolle
- Eine abgeschlossene Ausbildung z. B. als BTA, MTA oder VMTA
- Erfahrung in der Mikrobiologie
- Präzise und schnelle Arbeitsweise
- Einsatzbereitschaft, Lernbereitschaft, Belastbarkeit und Flexibilität
- Bereitschaft zu Wochenenddiensten
- Gute Deutsch- und/oder Englischkenntnisse
Laborant für unser Mikrobiologielabor Lebensmittel Auswertung (m/w/d)
(m/w/d) | Vollzeit, Teilzeit
Details zur Stelle
Mitarbeiter im Lager (m/w/d)
(m/w/d) | Vollzeit
Details zur Stelle
- Waren professionell annehmen und prüfen:
Du nimmst eingehende Lieferungen sorgfältig entgegen, kontrollierst diese auf Vollständigkeit und Qualität und stellst eine ordnungsgemäße Dokumentation sicher. - Materialien zuverlässig ein- und auslagern:
Du sorgst dafür, dass bestellte Materialien strukturiert eingelagert und termingerecht bereitgestellt werden – damit alle Abläufe reibungslos funktionieren. - Materialwirtschaftssystem pflegen:
Du erfasst und aktualisierst Bestände in unserem System und trägst so zu einer transparenten und verlässlichen Lagerorganisation bei. - Ordnung und Sauberkeit sicherstellen:
Du kümmerst dich um die Sauberhaltung des Außenlagers und übernimmst Entsorgungstätigkeiten verantwortungsbewusst und gewissenhaft
- Du arbeitest strukturiert und sorgfältig:
Du behältst auch bei hohem Arbeitsaufkommen den Überblick und gehst Aufgaben gewissenhaft an. - Du packst gerne mit an:
Du arbeitest engagiert, zuverlässig und eigenverantwortlich. - Du bringst Motivation und Teamgeist mit:
Du hast Freude an praktischer Arbeit und trägst mit deiner positiven Einstellung zu einem guten Miteinander bei. - Erste Erfahrungen im Lagerbereich, gerne auch Quereinsteiger.
- Gute Deutschkenntnisse für eine klare und sichere Kommunikation im Arbeitsalltag
Teamleitung Nährmedienherstellung und Laborservice (m/w/d)
(m/w/d) | Vollzeit
Details zur Stelle
- Abgeschlossene Berufsausbildung im technischen oder handwerklichen Bereich (z. B. Lebensmitteltechniker)
- Erfahrung in Führung und Organisation von Teams
- Freude an strukturiertem Arbeiten und Organisation
- Einsatzbereitschaft, Belastbarkeit und Flexibilität
- Gute Deutsch- und Englischkenntnisse


Wofür wir stehen
„Bei uns steht der Mensch im Mittelpunkt – ob Mitarbeiter oder Kunde. Wir stehen für Schnelligkeit und Zuverlässigkeit, aber wir wissen: Nur als Team können wir das erreichen.
Unsere Stärke liegt in der Zusammenarbeit – sie schafft nicht nur Ergebnisse, die zählen, sondern auch ein Arbeitsklima, das begeistert und zum Erfolg führt.“
Reiner Schmider, Julia Paustian und Paul Andrei
Geschäftsleitung
Unsere Werte und Arbeitsweise
Was dich bei uns erwartet

Moderner Arbeitsplatz
Wir setzen auf moderne Arbeitsplätze. Besonderen Wert legen wir auf die Weiter-
entwicklung, Transparenz und Spaß bei der Arbeit

Ein großartiges Team
Wir begegnen uns mit Respekt und arbeiten auf Augenhöhe miteinander. Unsere starken Führungskräfte fördern den Zusammenhalt, den Austausch und eine offene Kommunikation.

Eine Aufgabe mit Sinn
Mission: Wir unterstützen unsere Kunden bei der Herstellung sicherer und hochwertiger Produkte. Damit leisten wir einen wichtigen Beitrag zu ihrem Erfolg und zum Verbraucherschutz. Das Wissen, Teil dieser Mission zu sein, motiviert uns, jeden Tag unser Bestes zu geben und weiter zu wachsen.

Weiterbildungen
Die Förderung deiner fachlichen und persönlichen Weiterbildung ist für uns eine Herzensangelegenheit. Dadurch werden wir
gemeinsam immer besser.

Flexibilität
Wir bieten dir flexible Arbeitszeiten, mobiles Arbeiten und kurze Entscheidungswege. Bei uns kannst du deine Ideen einbringen und dein Arbeitsumfeld mitgestalten.

Klare Prozesse
Mit Hilfe einer guten Organisation und klaren Strukturen sorgen wir für eine gute Kommunikation im Unternehmen sowie mit unseren Kunden. So macht Arbeiten Spaß!
Benefits
Natürlich bieten wir dir auch zahlreiche Benefits.
flexible Arbeitszeiten
angemessenes Gehalt
betriebliche Altersvorsorge
gesundheitsfördernde Maßnahmen
Kostenfreie Getränke & Pausenräume
tolle Events
30 Urlaubstage
firmeneigene Parkplätze
Individuelle Entwicklungsprogramme
Jobbike & Zuschüsse zu Fahrtkosten
Dein Einstieg bei BAV
Wir begleiten dich – von Anfang an.
Ob als Berufseinsteiger oder mit Erfahrung – bei uns findest du sofort Anschluss. Wir sorgen dafür, dass du dich willkommen fühlst und begleiten dich auf deinem individuellen Weg in unserem Team.
Willkommen im Team
Wir legen großen Wert auf ein herzliches Willkommen. Bei uns wirst du Teil einer Gemeinschaft, die dir hilft, dich schnell einzuleben und deine Stärken einzubringen.
Individuelle Einarbeitung
Vom ersten Tag an stehen dir erfahrene Kollegen und Kolleginnen zur Seite. Mit einem klar strukturierten Einarbeitungsplan machen wir dich mit unseren Abläufen und unserem Team vertraut.
Schritt für Schritt wachsen
Wir fördern deine Weiterentwicklung, damit wir gemeinsam besser und erfolgreicher werden.

schnell und effizient
Der Bewerbungsprozess

Bewerbung
Bewirb dich ganz unkompliziert über unser digitales Formular. So bekommen wir einen ersten Eindruck von dir und deiner aktuellen Situation.

Kennenlerngespräch
Im ersten Gespräch lernen wie uns kennen und tauschen uns über deine Erfahrungen aus.

Persönliches Gespräch
Wir laden dich ein, unser Team und die Räumlichkeiten persönlich kennenzulernen. Anschließend besprechen wir die weiteren Einzelheiten.
FAQ
Noch offene Fragen?
Welche Aufgaben erwarten mich im Laborbereich?
Je nach Aufgabenbereich bereitest du Proben vor, führst Analysen durch oder wertest Ergebnisse aus. Dabei wirst du mit abwechslungsreichen Aufgaben und modernster Technologie arbeiten.
Gibt es Entwicklungsmöglichkeiten bei BAV?
Natürlich! Wir unterstützen deine persönliche und fachliche Weiterentwicklung durch gezielte Schulungen, Seminare und Förderungen. Unserer Führungskräfte haben bei uns als Mitarbeiter gestartet und sich gemeinsam mit uns gewachsen.
Ist das BAV Institut auch für Quereinsteiger geeignet?
Ja! Wir heißen Quereinsteiger willkommen, die Interesse an Qualitätskontrolle und Laborarbeit haben. Durch eine strukturierte Einarbeitung und die Unterstützung erfahrener Kollegen bereiten wir dich bestens auf deine neue Herausforderung vor.
Was macht die Arbeit bei BAV besonders?
Bei uns bist du mehr als nur Teil eines Labors – du bist Teil einer engagierten Gemeinschaft, die täglich für unsere Kunden und den Verbraucherschutz einsetzt. Damit leisten wir einen wichtigen Beitrag zur Gesellschaft, denn BAV-geprüfte Produkte stehen in jedem Haushalt. Hier hast du die Möglichkeit, mit deiner Arbeit einen echten Mehrwert zu schaffen.
Was macht das BAV Institut?
Das BAV Institut ist ein führendes Labor für Qualitätskontrolle und Hygieneüberwachung in den Bereichen Lebensmittel, Kosmetik und Arzneimittel. Wir führen mikrobiologische und chemische Analysen durch, beraten unsere Kunden in Fragen der Qualitätssicherung und bieten praxisorientierte Schulungen an. Mit modernster Technik und einem starken Team sorgen wir dafür, dass Produkte sicher und den höchsten Standards entsprechend auf den Markt kommen.
Welche Eigenschaften sollte ich mitbringen, um gut ins Team zu passen?
Wir suchen Menschen, die Teamgeist, Engagement und eine Leidenschaft für Präzision und Qualität mitbringen. Eigeninitiative sowie die Bereitschaft, Verantwortung zu übernehmen, sind ebenfalls wichtige Voraussetzungen, um gut in unser Team zu passen.



Über das BAV Institut
Gemeinsam für sichere und qualitativ hochwertige Produkte in den Bereichen Lebensmittel, Kosmetik und Arzneimittel
Seit unserer Gründung im Jahr 1997 prüfen wir im Auftrag von Lebensmittel-, Kosmetik- und Arzneimittelbetrieben deren Produkte auf Qualität und Sicherheit.
Was uns besonders auszeichnet, ist nicht nur unsere moderne Labortechnologie, sondern vor allem unsere Werte: Teamgeist, Offenheit und eine klare Ausrichtung auf Stabilität. Dabei steht unser Motto „schnell und zuverlässig“ stets im Vordergrund.
Unsere Arbeit ist mehr als nur Laboranalyse – sie trägt aktiv zur Sicherheit und Qualität von Produkten bei, die Millionen Menschen täglich nutzen. Diese Verantwortung treibt uns an, jeden Tag unser Bestes zu geben.
Wir bieten dir die Chance, in einem dynamischen, zukunftsorientierten und sicherem Unternehmen zu arbeiten, das kontinuierlich in seine Mitarbeiter investiert. Unsere engagierten Mitarbeiter sind das Herzstück unseres Erfolgs.
Werde Teil unserer Zukunft!
Über das BAV INstitut
Gemeinsam für sichere und qualitativ hochwertige Produkte in den Bereichen Lebensmittel, Kosmetik und Arzneimittel
Seit unserer Gründung im Jahr 1997 prüfen wir im Auftrag von Lebensmittel-, Kosmetik- und Arzneimittelbetrieben deren Produkte auf Qualität und Sicherheit.
Was uns besonders auszeichnet, ist nicht nur unsere moderne Labortechnologie, sondern vor allem unsere Werte: Teamgeist, Offenheit und eine klare Ausrichtung auf Stabilität. Dabei steht unser Motto „schnell und zuverlässig“ stets im Vordergrund.
Unsere Arbeit ist mehr als nur Laboranalyse – sie trägt aktiv zur Sicherheit und Qualität von Produkten bei, die Millionen Menschen täglich nutzen. Diese Verantwortung treibt uns an, jeden Tag unser Bestes zu geben.
Wir bieten dir die Chance, in einem dynamischen, zukunftsorientierten und sicherem Unternehmen zu arbeiten, das kontinuierlich in seine Mitarbeiter investiert. Unsere engagierten Mitarbeiter sind das Herzstück unseres Erfolgs.
Werde Teil unserer Zukunft!

















